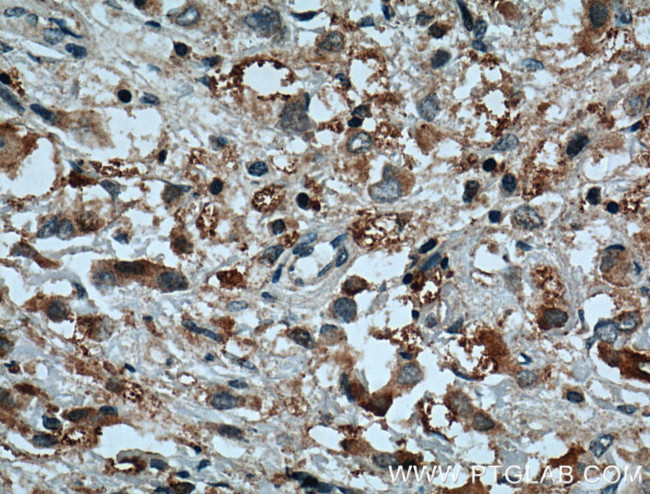
C10orf18 Antibody in Immunohistochemistry (Paraffin) (IHC (P))

Search
Proteintech
C10orf18 Polyclonal Antibody
{{$productOrderCtrl.translations['antibody.pdp.commerceCard.promotion.promotions']}}
{{$productOrderCtrl.translations['antibody.pdp.commerceCard.promotion.viewpromo']}}
{{$productOrderCtrl.translations['antibody.pdp.commerceCard.promotion.promocode']}}: {{promo.promoCode}} {{promo.promoTitle}} {{promo.promoDescription}}. {{$productOrderCtrl.translations['antibody.pdp.commerceCard.promotion.learnmore']}}
产品信息
20420-1-AP
种属反应
宿主/亚型
分类
类型
抗原
偶联物
形式
浓度
纯化类型
保存液
内含物
保存条件
运输条件
产品详细信息
Immunogen sequence: NSQRNHTVS FHLNKLKYNS TVKESRNDIS LILNEYAEFN KVMKNSNQFI FQDKELNDVS GEATAQEMYL PFPGRSASYE DIIIDVCTNL HVKLRSVVKE ACKSTFLFYL VETEDKSFFV RTKNLLRKGG HTEIEPQHFC QAFHRENDTL IIIIRNEDIS SHLHQIPSLL KLKHFPSVIF AGVDSPGDVL DHTYQELFRA GGFVISDDKI LEAVTLVQLK EIIKILEKLN GNGRWKWLLH YRENKKLKED ERVDSTAHKK NIMLKSFQSA NIIELLHYHQ CDSRSSTKAE ILKCLLNLQI QHIDARFAVL LTDKPTIPRE VFENNGILVT DVNNFIENIE KIAAPFRSSY W (2081-2430 aa encoded by BC001759)
靶标信息
FAM208B is a protein coding gene.
仅用于科研。不用于诊断过程。未经明确授权不得转售。
篇参考文献 (0)
生物信息学
蛋白别名: family with sequence similarity 208, member B; Protein TASOR 2
基因别名: bA318E3.2; C10orf18; FAM208B; KIAA2006; TASOR2
UniProt ID: (Human) Q5VWN6
Entrez Gene ID: (Human) 54906